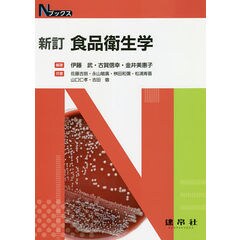

書籍 その他の商品一覧
4,561 ~ 4,620 / 10,317 件
表示形式
を変更
を変更
- リスト
- グリッド
※「ポイント最大○倍」と記載された商品については、各商品ごとに設定されたキャンペーン条件(エントリー含む)によりポイント付与倍率が決定します。
ポイントアップの条件は各商品に設定されたキャンペーンにより異なりますので、詳細は各商品詳細ページよりご確認ください。
ポイントアップの条件は各商品に設定されたキャンペーンにより異なりますので、詳細は各商品詳細ページよりご確認ください。
おすすめクーポン付き商品
4,561 ~ 4,620 / 10,317 件